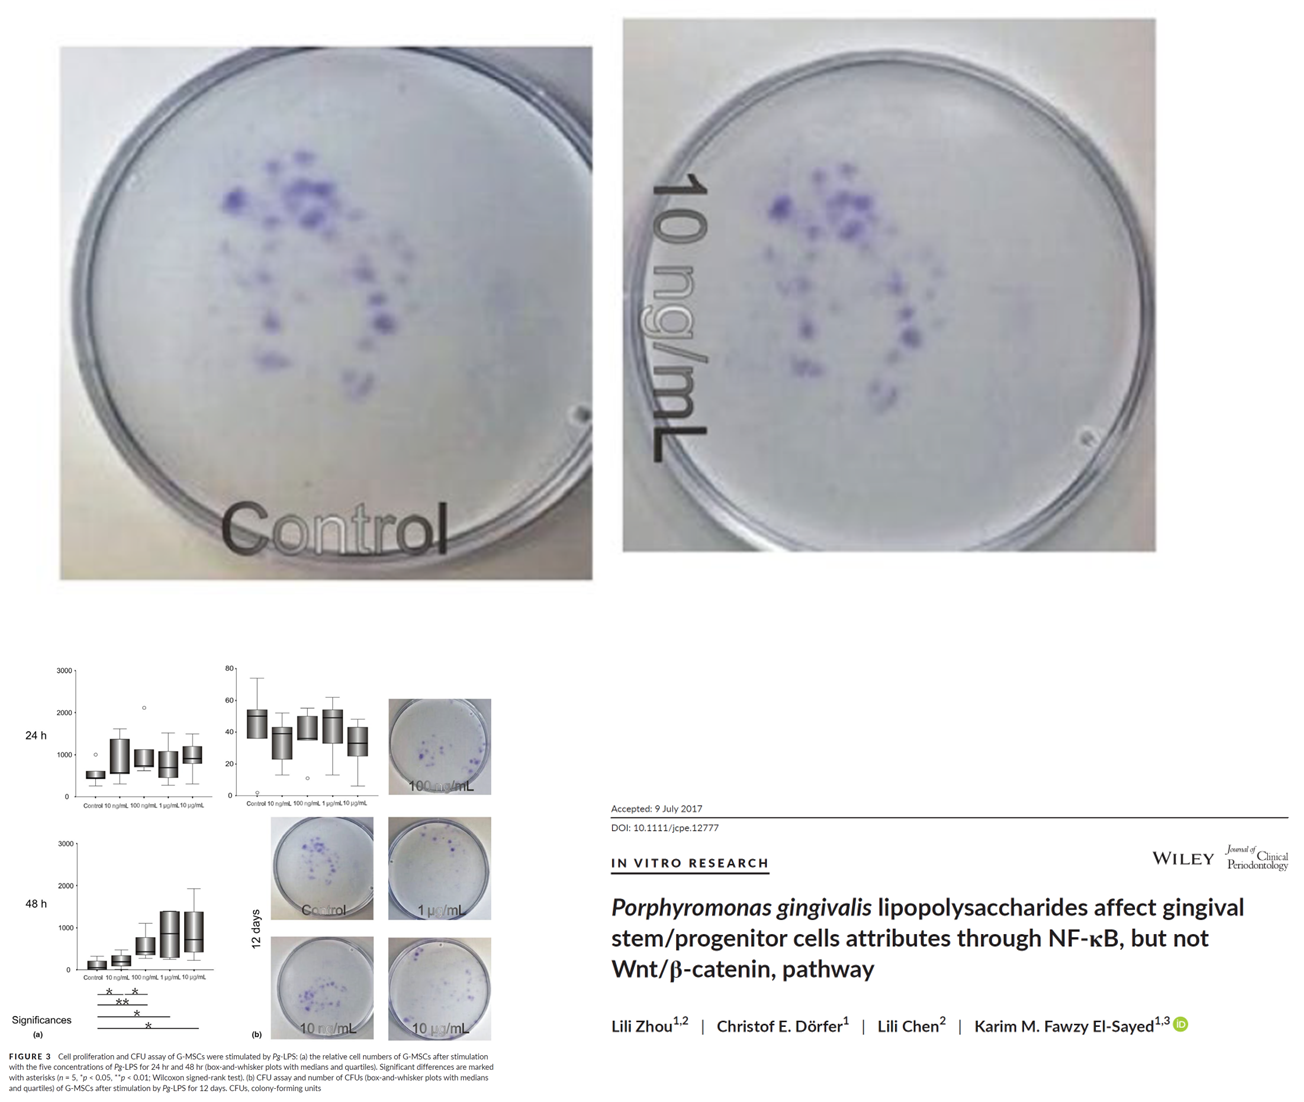

Schneider Shorts of 13 March 2026 – German university welcomes the real victims of war, bad dentistry and bad cancer research in Germany (with major input from USA), fraud and patient abuse in Italy, and finally, with two papermillers in Poland – one very successful, another hit by retractions.
Table of Discontent
Science Elites
- Researchers affected by war in Ukraine and beyond – fellowships in Bochum for the real victims of war
- First dentist ever – clean teeth and dirty science in Kiel
- Fraudulent misrepresentation – fake science and patient abuse in Turin
Scholarly Publishing
- Unable to explain with certainty – concerns expressed for Andres Klein-Szanto and his German friend
- More transparent and consistent – Stefan Wuttke saves European science!
Retraction Watchdogging
- Provincial Herb Festival – Agnieszka Najda bought from cheapest papermills
Science Elites
Researchers affected by war in Ukraine and beyond
Fun never ends at the Ruhr University of Bochum (RUB) in Germany (read about that other fun here, here, here and here). Now, their humanities department decided to support the real victims of russia’s genocidal war on Ukraine, and those are of course: the russians!
Here a current open call for fellowships with the Osteuropa-Kolleg NRW (College of Eastern Europe North Rhine-Westphalia) at RUB and its neighbouring universities TU Dortmund and University of Duisburg-Essen, aimed at “postdoctoral researchers affected by the war in Ukraine and beyond“. It was shared by Sören Urbansky, RUB professor for East European history, most recently a week ago on LinkedIn.

The fellowships are sponsored by the russian Zimin Foundation, whihc was founded by the late Dmitry Zimin, who got rich from his VimpelCom (VEON) telecommunications company, the business and the charity are now run by his son. Zimin Foundation was banned in russia in 2022.
The historian Franziska Davies recently blogged about russo-centrism in academia, and specifically mentioned this fellowship call:
“A little research quickly revealed that the majority of these scholarships seem, so far, to have gone to Russians. This is hardly surprising given the way the call is phrased. The fact that the Ruhr University cooperates with the Russian foundation Zimin to finance this scholarship will likely deter many Ukrainians further.
I (like others) pointed this out to those responsible for the programme, but they saw no need for action. The only change since then is that “the war in Ukraine” has been replaced by “Russia’s war of aggression.”
Time to overcome Western arrogance – by Franziska Davies
“Russia can be defeated; Russia has been defeated before. The question is not one of possibility, but of political will.” – Franziska Davies
Well, let’s see what great russian scholars got this fellowship then.
Meet Sergey Chernyshov, Fedor Stepun Fellow of 2024, and former member of Urbansky’s group. Here he is on Facebook, sharing his hatred for Ukrainian and Syrian refugees and his love for the German far-right party AfD, as archived by Germany-based Ukrainian journalist Nikolai Klimeniouk in January 2025:

Urbansky replied on Facebook a year ago, expressing his ” disappointment and shock” about Chernyshev’s posts and assuring: “To date, the employee has not attracted attention for making negative or derogatory comments about refugees or other crude statements“. Chernyshev himself replied on Facebook in russian, to openly threaten Klimeniouk with criminal libel lawsuits.
Was it a German attempt at re-education, because the rascist AfD-lover Chernyshev studied under Urbansky’s tutelage “internal decolonization of russia”:

In February 2025, the hero russian dissident Chernyshev contributed an article to exile russian website Russia.post, titled “Russian Education Further Transforming into Kremlin Ideological Instrument“, and another one on the same topic to Moscow Times. And in March 2025, two months after he was exposed as rascist, racist and AfD-lover, the Osteuropa-Kolleg NRW let Chernyshev organise an online conference, titled “Painful changes in russian education“, supervised by the RUB professor Nikolaj Plotnikov. Every single speaker and organiser was russian, including Plotnikov, who is not only director of the Osteuropa-Kolleg NRW and member of RUB’s Lotman Institute for Russian Culture Studies, but also the organiser of this Feodor-Stepun-Fellowhip program for all those good russians. On 20 April 2022, weeks after the monstrous crimes committed in Bucha became known, Plotnikov publicly defended russians:

In Bochum, they are apparently convinced that it is the Ukrainians who are the real problem, those rotten russophobic nationalists who refuse to embrace their russian big brothers, while the latter are of course all totally innocent, because it is putin alone who is responsible for the war crimes in Ukraine. Look at this, from March 2022 and still proudly online:

“Cohesion in difficult times
The Study Bridge to Eastern Europe program with students from Russia and Ukraine continues – for good reason. Participants report.
Especially in the current times of war in Ukraine, there are increasing numbers of voices calling for all relations with Russia to be severed. The fact that this would not make sense in every case and could even affect the wrong people is shown by the Studienbrücke program” (RUB)
First dentist ever
Now, to quality research from German university medicine!
Professor Christof Dörfer is Dean for Studies at the Dentistry School of the University of Kiel and director of the Clinic for Dentistry and Periodontology of the University Clinic Schleswig-Holstein. Karim Fawzy El‐Sayed is senior physician at Dörfer’s clinic, head of the research laboratory there and simultaneously professor at Cairo Universiry and owner of a dental clinic in Cairo. As University of Kiel proudly informed in 2014, El-Sayed is also laureate of the Egyptian State Prize for Medical Sciences, “as the first dentist ever“.
Mohamed Mekhemar , Johannes Tölle, Christof Dörfer, Karim Fawzy El‐Sayed TLR3 ligation affects differentiation and stemness properties of gingival mesenchymal stem/progenitor cells Journal of Clinical Periodontology (2020) doi: 10.1111/jcpe.13323

Dörfer, El-Sayed, another senior physician named Mohamed Mekhemar, and a whole troupe of important German professors of dentistry:
Karim M. Fawzy El-Sayed , Amira Bittner , Kristina Schlicht, Mohamed Mekhemar , Kim Enthammer, Marc Höppner , Martha Es-Souni , Juliane Schulz, Matthias Laudes, Christian Graetz , Christof E. Dörfer , Dominik M. Schulte Ascorbic Acid/Retinol and/or Inflammatory Stimuli’s Effect on Proliferation/Differentiation Properties and Transcriptomics of Gingival Stem/Progenitor Cells Cells (2021) doi: 10.3390/cells10123310

Fan Zhang , Misi Si , Huiming Wang , Mohamed K. Mekhemar , Christof E. Dörfer , Karim M. Fawzy El-Sayed IL-1/TNF-αInflammatory and Anti-Inflammatory Synchronization Affects Gingival Stem/Progenitor Cells’ Regenerative Attributes Stem Cells International (2017) doi: 10.1155/2017/1349481
Here another study by Dörfer and El-Sayed:
Lili Zhou , Christof E Dörfer , Lili Chen , Karim M Fawzy El-Sayed Porphyromonas gingivalis lipopolysaccharides affect gingival stem/progenitor cells attributes through NF-κB, but not Wnt/β-catenin, pathway Journal of Clinical Periodontology (2017) doi: 10.1111/jcpe.12777
More image reuse in dentistry studies from Kiel:
- Karim M Fawzy El-Sayed , Sebastian Paris, Christian Graetz , Neemat Kassem , Mohamed Mekhemar, Hendrick Ungefroren , Fred Fändrich , Christof Dörfer Isolation and characterisation of human gingival margin-derived STRO-1/MACS(+) and MACS(-) cell populations International Journal of Oral Science (2015) doi: 10.1038/ijos.2014.41
- K Fawzy El-Sayed, C Graetz, T Kohnlein, M Mekhemar, C Dorfer Effect of total sonicated Aggregatibacter actinomycetemcomitans fragments on gingival stem/progenitor cells Medicina Oral Patología Oral y Cirugia Bucal (2018) doi: 10.4317/medoral.22661

An image from the 2018 paper above somehow reappeared here:
Karim M. Fawzy El‐Sayed , Daniela Hein , Christof E. Dörfer Retinol/inflammation affect stemness and differentiation potential of gingival stem/progenitor cells via Wnt/β‐catenin Journal of Periodontal Research (2019) doi: 10.1111/jre.12643

Another paper by Dörfer and El-Sayed (Bashir et al 2023) was subject to citation extortion by a reviewer at MDPI, a practice described here:
The Extortionists, by M. Angeles Oviedo-Garcia
“The preference of Thippa Reddy Gadekallu et al. (Abdul Rehman Javed, Celestine O. Iwendi, Sharnil Nitin Pandya and Gaurav Jay Dhiman) for coercive citation and copy-pasting their review comments” – Maria de los Ángeles Oviedo García
The reviewer Narsimha Mamidi, a papermilling nobody based in USA, demanded citation of three of his papers, one with the known papermiller Seeram Ramakrishna. Dörfner and El-Sayed complied, the latter assured on PubPeer: “We authors, confirm that we authors have no personal connection in any capacity to the reviewer Mamidi.”
I wrote to Dörfer, and on 2 March 2026 he replied to me (translated):
“Thank you for your email and for bringing the allegations to our attention. We will check the matter and get back to you as soon as possible.”
No follow-up since.
Fraudulent misrepresentation
In Italy, the ophthalmologist Raffaele Nuzzi, hospital director and associate professor at the University of Turin, was sentenced in 2024 to 2.5 years prison, for “aggravated assault and fraudulent misrepresentation“, i.e. for mutilating his patients. In July 2025, the sentence was reduced to 9 months and 20 days and suspended, as La Stampa reported. RAI News wrote in November 2024 (translated):
“About ten patients, injured parties in the proceedings, ended up in the operating room for a different surgery than the one planned. Operations for the obstruction of the nasolacrimal duct and epiphora ended with the mutilation of the canalicular system, which regulates the outflow of tears, caused according to the accusation by the removal of the lacrimal sac.”
Nuzzi is therefore a good example that bad doctors are also bad scientists. He has currently only two papers on PubPeer, but still:
- Loredana Bergandi, Oleksii A Skorokhod, Federica Franzone, Rosalba La Grotta, Evelin Schwarzer, Raffaele Nuzzi Induction of oxidative stress in human aqueous and vitreous humors by Nd:YAG laser posterior capsulotomy International Journal of Ophthalmology (2018) doi: 10.18240/ijo.2018.07.12
- Loredana Bergandi, Oleksii A Skorokhod , Rosalba La Grotta , Evelin Schwarzer , Raffaele Nuzzi Oxidative Stress, Lipid Peroxidation, and Loss of Hyaluronic Acid in the Human Vitreous Affected by Synchysis Scintillans Journal of Ophthalmology (2019) doi: 10.1155/2019/7231015

The first author Loredana Bergandi, also at University of Turin, has more stuff on PubPeer, 7 papers currently. This here was fabricated very professionally, applause to Bergandi’s talents:
Loredana Bergandi, Eleonora Mungo , Rosa Morone , Ornella Bosco, Barbara Rolando, Sophie Doublier Hyperglycemia Promotes Chemoresistance Through the Reduction of the Mitochondrial DNA Damage, the Bax/Bcl-2 and Bax/Bcl-XL Ratio, and the Cells in Sub-G1 Phase Due to Antitumoral Drugs Induced-Cytotoxicity in Human Colon Adenocarcinoma Cells Frontiers in Pharmacology (2018) doi: 10.3389/fphar.2018.00866



The French researcher Sophie Doublier (now at eFrei- Grande école du numérique in Paris) used to be postdoc and assistant professor in Turin. She has much more bad stuff on PubPeer, all with Italian collaborators, often with the Turin professor Dario Ghigo, presumably her former boss. Ghigo also has some common papers with Nuzzi, but those weren’t flagged on PubPeer (yet). Now, how about a paper by Ghigo and his former mentee Bergandi, where one gel band was used 3 times in one figure?
Loredana Bergandi , Marco Cordero , Matteo Anselmino , Gaetana Ferraro , Laura Ravera , Paola Dalmasso , Corrado Moiraghi , Gian Paolo Trevi , Dario Ghigo, Amalia Bosia, Serena Bergerone Altered nitric oxide/cGMP platelet signaling pathway in platelets from patients with acute coronary syndromes Clinical Research in Cardiology (2010) doi: 10.1007/s00392-010-0157-3

Aneurus inconstans: “Figure 5: three bands describing different conditions appear much more similar than expected (red boxes). Differences are limited to dark areas that seem to be the result of digital editing.”
Ghigo is 71 years old now and apparently retired. He has 20 bad papers on PubPeer, here another one with Bergandi:
Loredana Bergandi , Gemma Basso , Francesca Evangelista , Stefano Canosa , Paola Dalmasso , Elisabetta Aldieri, Alberto Revelli, Chiara Benedetto, Dario Ghigo Inducible Nitric Oxide Synthase and Heme Oxygenase 1 Are Expressed in Human Cumulus Cells and May Be Used as Biomarkers of Oocyte Competence Reproductive Sciences (2014) doi: 10.1177/1933719114525268

Which brings us to another medicine professor at University of Turin, a former PhD student of Ghigo, and I wrote about her in December 2025 Shorts. It is the disastrous Chiara Riganti, who is not only a massive cheater but also a pathological liar, with by now almost 60 outrageously fake papers on PubPeer. Riganti and Berganti are named on joint patents with Ghigo.
Here a fake paper by Bergandi and Riganti, your guess is as good as mine about who faked this:
Martina Schiavello, Elena Gazzano, Loredana Bergandi, Francesca Silvagno, Roberta Libener , Chiara Riganti, Elisabetta Aldieri Identification of Redox-Sensitive Transcription Factors as Markers of Malignant Pleural Mesothelioma Cancers (2021) doi: 10.3390/cancers13051138

Four TBP bands of Figure 1A have been squeezed vertically and reused in Figure 4C for describing Tubulin (blue boxes).
Four Ref-1 bands of Figure 6A have been mirrored vertically and resized in Figure 3A, where they describe SOD2 (pink boxes).”
By the way, here is a fake paper by Ghigo, Riganti and Doublier:
Sophie Doublier, Dimas C Belisario , Manuela Polimeni , Laura Annaratone , Chiara Riganti , Elena Allia , Dario Ghigo, Amalia Bosia, Anna Sapino HIF-1 activation induces doxorubicin resistance in MCF7 3-D spheroids via P-glycoprotein expression: a potential model of the chemo-resistance of invasive micropapillary carcinoma of the breast BMC Cancer (2012) doi: 10.1186/1471-2407-12-4


And another one by this trio:
Sophie Doublier, Chiara Riganti, Claudia Voena , Costanzo Costamagna , Elisabetta Aldieri , Gianpiero Pescarmona , Dario Ghigo, Amalia Bosia RhoA silencing reverts the resistance to doxorubicin in human colon cancer cells Molecular cancer research (2008) doi: 10.1158/1541-7786.mcr-08-0251

But I am entering a rabbit hole of Italian fraud, best to stop now. Anyway, do we believe their patients are in safe hands? Like with Nuzzi?
Scholarly Publishing
Unable to explain with certainty
A study from Charité Berlin in Germany recently received an Expression of Concern. It was flagged by the pseudonymous sleuth Claire Francis almost 13 years ago, in 2013.
This is the paper, the last author is Karl-Heinz Braunewell, former researcher at Charité Berlin, who then went to University of Alabama Birmingham in USA, with another lab at Ruhr University of Bochum in Germany, he now focusses on his consulting company Power Brains LLC. The other senior author is Andres Klein-Szanto, US researcher from Argentina with a Hungarian name, until his retirement as emeritus in 2022 at the age of around 80, he was professor at Fox Chase Cancer Center in Philadelphia, USA.
Katharina Schönrath , Wensheng Pan , Andres J. Klein-Szanto , Karl-Heinz Braunewell Involvement of VILIP-1 (visinin-like protein) and opposite roles of cyclic AMP and GMP signaling in in vitro cell migration of murine skin squamous cell carcinoma Molecular Carcinogenesis (2011) doi: 10.1002/mc.20707


Figure 5C. NPR-B panel. There is a vertical, grey streak/vertical change in background between lanes 2 and 3.”

On 6 March 2026, the publisher Wiley issued this Expression of Concern:
“The Expression of Concern has been agreed upon following concerns raised by a third party. An investigation identified duplication between the +1 μM KT5823 image included in Figure 6D and an image published subsequently in another journal by the same author group. Evidence of splicing was also identified in several western blots. The author acknowledged that the image in Figure 6D had been duplicated, but due to the length of time that has passed, was unable to provide the original data or explain with certainty how the duplication occurred. The authors also stated that several of the western blots in the study had been spliced without delineating the splice sites, a practice that was acceptable under the journal’s standards at the time of publication. The journal has decided to issue an Expression of Concern to inform readers.”
This is the PLOS One paper mentioned above, by the same authors (including Katharina Schönrath, who still works at Charite), it received a large Correction in December 2013 because “Figures 1B and 5A in the article are generated using bands from different blots”, the authors admitted that the gel bands “were rearranged“. Well, maybe a retraction would be a better option, what with this new evidence:
Katharina Schönrath , Andres J. Klein-Szanto, Karl H. Braunewell The putative tumor suppressor VILIP-1 counteracts epidermal growth factor-induced epidermal-mesenchymal transition in squamous carcinoma cells PLOS One (2012) doi: 10.1371/journal.pone.0033116

Braunewell and Klein-Szanto have in total 5 common papers on PubPeer, PLOS One also corrected in October 2013 their study Fu et al 2008, because “most site panels were not run in adjacent lanes but were cut and pasted“.
Carlo Croce: from fake science to fake art
“The sockpuppets went on to argue that Croce’s fake results had been vindicated by subsequent replications, making him guilty of nothing more than excessive zeal in the cause of righteousness. ” – Smut Clyde
Thanks to the efforts by Claire Francis and other sleuths, Klein-Szanto has over 40 papers on PubPeer. In fact, his papers were mentioned on this website before, because of his celebrity coauthors – a who-is-who list of American fake science: Wafik El-Deiry, Antonio Giordano, J. Silvio Gutkind and Carlo Croce. This with Giordano recently received an Expression of Concern also, I made some additional illustrations:
F Rizzolio , C Lucchetti , I Caligiuri , I Marchesi , M Caputo , A J Klein-Szanto , L Bagella , M Castronovo , A Giordano Retinoblastoma tumor-suppressor protein phosphorylation and inactivation depend on direct interaction with Pin1 Cell Death & Differentiation (2012) doi: 10.1038/cdd.2011.202


The Expression of Concern from 2 December 2025 went:
“The Editors-in-Chief would like to alert the readers that concerns have been raised regarding some of the western blots presented in the figures and supplementary materials, specifically:
- Fig. 7a MCF7 and OVCAR3 HSP70 blots appear highly similar.
- Fig. S5 pS780 lanes 5 and 7 appear highly similar.
- Fig. S10 α-tubulin appears highly similar to Fig. 7a HSP70.
The authors have stated that an incorrect blot was presented in Fig. 7a for OVCAR3 HSP70 and that the loading control in Fig. S10 was mislabelled as α-tubulin instead of HSP70, and provided supporting full blot scans. However, due to the number of potential errors in the article, readers are advised to intepret these data with caution.”
Klein-Szanto already has three retractions, all from 2017/2018 and all with Croce and the Neapolitan crook Alfredo Fusco: Fedele et al 2006, Fedele et al 2011 and Pero et al 2012.
Wafik El Deiry, the anti-qualified Science Guardian
Both Harvey Risch and Wafik El Deiry are perfectly anti-qualified candidates to lead the National Cancer Institute.
Three authors here, what do you think, who is responsible for these fake figures, Klein-Szanto, El-Deiry (now full-time antivaxxer) or their Swedish mentee Niklas Finnberg, now pharma executive?
Niklas Finnberg, Andres J P Klein-Szanto, Wafik S El-Deiry TRAIL-R deficiency in mice promotes susceptibility to chronic inflammation and tumorigenesis The Journal of clinical investigation (2008) doi: 10.1172/jci29900


In the bottom two rows, it appears that the PI panels of Etoposide 1 uM and Etoposide + TRAIL might have been switched.”
Here is Klein-Szanto with Garret FitzGerald, department chair at Perelman School of Medicine of University of Pennsylvania, and someone named Colin Funk, biotech entrepreneur and professor at Queen’s University in Kingston, Canada. All three men were at that time at Fox Chase Cancer Center:
Ying Yu , Jinjin Fan , Yiqun Hui , Carol A. Rouzer , Lawrence J. Marnett , Andres J. Klein-Szanto, Garret A. FitzGerald , Colin D. Funk Targeted cyclooxygenase gene (ptgs) exchange reveals discriminant isoform functionality Journal of Biological Chemistry (2007) doi: 10.1074/jbc.m609930200


Same team, first author again is their PhD student Ying Yu, now with pharma industry:
Ying Yu , Yan Cheng , Jinjin Fan , Xin-Sheng Chen , Andres Klein-Szanto, Garret A. Fitzgerald , Colin D. Funk Differential impact of prostaglandin H synthase 1 knockdown on platelets and parturition The Journal of clinical investigation (2005) doi: 10.1172/jci23683

Actinopolyspora biskrensis: “a duplicated feature in the last lane” , Fig 1B
Here they are all again, the paper was flagged last year:
Ying Yu , Jinjin Fan , Xin-Sheng Chen , Dairong Wang , Andres J Klein-Szanto, Robert L Campbell , Garret A FitzGerald, Colin D Funk Genetic model of selective COX2 inhibition reveals novel heterodimer signaling Nature Medicine (2006) doi: 10.1038/nm1412

Funk has some more problematic papers on PubPeer, and so does Fitzgerald (PubPeer record). But we wish to talk about Klein-Szanto, have more fake gels from his lab:

Fig 4

It is rather likely that Klein-Szanto’s research was subject to an institutional investigation at Fox Chase, maybe some student was thrown under the bus. In any case, in 2019 Klein-Szanto corrected 3 papers from his own lab. Very dishonestly so.
This was corrected in April 2019, to briefly mention that “Figs. 1C and 3B are missing splice lines between U87MG and U118MG“, actually Figure 1C was completely fake:
Javier Mercapide , Ricardo Lopez De Cicco , Daniel E Bassi , Javier S Castresana , Gary Thomas , Andres JP Klein-Szanto Inhibition of furin-mediated processing results in suppression of astrocytoma cell growth and invasiveness Clinical Cancer Research (2002) 8 (6): 1740–1746.

Also in the next case, the authors only admitted in an outrageously fraudulent Correction from April 2019 that “Fig. 4A is missing a splice line between SCC15 and SCC71“. Yet both not only the authors but also the editors knew exactly what was wrong, the PubPeer evidence was posted in 2015:
Ricardo López López De Cicco , James C. Watson , Daniel E. Bassi , Samuel Litwin , Andrés J. Klein-Szanto Simultaneous expression of furin and vascular endothelial growth factor in human oral tongue squamous cell carcinoma progression Clinical Cancer Research (2004) doi: 10.1158/1078-0432.ccr-03-0670


Here is that other paper, commented on PubPeer between 2013 and 2017 and never even corrected, maybe it was Ricardo López De Cicco who met that proverbial bus:
Ricardo López De Cicco , Daniel E. Bassi , Stanley Zucker , Nabil G. Seidah , Andrés J.P. Klein-Szanto Human carcinoma cell growth and invasiveness is impaired by the propeptide of the ubiquitous proprotein convertase furin Cancer Research (2005) doi: 10.1158/0008-5472.can-04-2820

Fig 1C and 5E
Also this paper by Klein-Szanto was corrected, both for stuff flagged on PubPeer in 2015 and for other things. The last author is the MD Anderson bigwig Virgil Craig Jordan, who died in 2024 aged 76, after having “revolutionized breast cancer treatments“:
Joan S Lewis-Wambi, Helen R Kim, Chris Wambi, Roshani Patel, Jennifer R Pyle, Andres J Klein-Szanto, V Craig Jordan Buthionine sulfoximine sensitizes antihormone-resistant human breast cancer cells to estrogen-induced apoptosis Breast Cancer Research (2008) doi: 10.1186/bcr2208

The Correction from June 2018 went (highlights mine):
“After the publication of this work [1] an error was noticed in Fig. 3a and Fig. 5a. In Fig. 3a, the TUNEL staining image for the E2-treated MCF-7:2A cells was accidentally duplicated for the image for the BSO-treated MCF-7:2A cells. We have repeated this experiment using the Click-it-TUNEL kit under the same conditions previously described in our original publication [1] and our results are consistent. […]
Similarly, we also noticed an error in the Western blot shown in Fig. 5a. Specifically, there was a duplication of the phospho-JNK blot for the MCF-7 cells and MCF-7:2A cells for the control, E2, and BSO-treated groups (top blot). To correct this error, we repeated this experiment using the same conditions described in our original publication [1] and the revised Fig. 5a is shown below. […] Our revisions validate our previous findings and are consistent with the conclusions stated in our original publication. We apologize for these two errors.”
They repeated experiments a decade later, with same cells and reagents. Funny how scientists can always do that, while totally unable to store raw data for longer than a week after publication.
Antonio Giordano and the Sbarro Pizza Temple
“The relentless defence of duplicated, fabricated or falsified data is, per se, a form of serious misconduct…” Antonio Giordano, President of Sbarro Pizza Institute at Temple University
Anyway, the authors forgot to explain this very inappropriate recycling from that same Fig 5A in a latter paper, and Jordan is too dead to explain it now:
Joan S. Lewis-Wambi, Ramona Swaby , Helen Kim, V. Craig Jordan Potential of l-buthionine sulfoximine to enhance the apoptotic action of estradiol to reverse acquired antihormonal resistance in metastatic breast cancer The Journal of Steroid Biochemistry and Molecular Biology (2009) doi: 10.1016/j.jsbmb.2008.12.016

Why, of course also Jordan has more on PubPeer, 12 papers in total, with little hope for a post-mortem editorial action. I’m not sure all these fabrications helped any women suffering from breast cancer, but they sure helped some important men in medicine to get very rich.
More transparent and consistent
Research reproducibility is in good and capable hands! Chemistry World, a magazine by Royal Society of Chemistry, informed on 6 March 2026:
“A computer file that stores information on how scientists synthesise and characterise metal–organic frameworks (MOFs) could standardise the reporting of such materials. These files offer a potential way to reduce the discrepancy between methods and help chemists recreate existing MOFs more easily. […]
Scientists at EU4MOFS have now developed a new file format to standardise the way that researchers report synthetic methods and properties of MOFs. […] The team hopes that such files will become a standard part of research papers to make the reporting of MOF synthesis more transparent and consistent.”
Magic crystals and Nobel Science rules
As one Nobelist retracted her Science paper, another Nobelist has stealthily corrected his. The correction opens new dimensions of probabilities and is indeed best kept hidden.
Here is the seminal study:
Ocean Cheung , Shun Tokuda , Damian Jędrzejowski , Evelyn Ploetz , Bettina Baumgartner , Marzena Pander , Fengxu Yang , Jack D. Evans , Romy Ettlinger , Stefan Wuttke , Dariusz Matoga Material Preparation Information File (MPIF): A Community‐Driven Standard for Reporting MOF Syntheses Advanced Materials (2026) doi: 10.1002/adma.202521420
EU4MOFs is a recent EU Commission funded project, and its Chair is Stefan Wuttke, a German native who used to work in Spain as Ikerbasque Research Professor at BCMaterials (where Ahmed Shalan used to run a papermill) and is now professor at AGH University of Krakow in Poland (where Marek Jaszczur runs a papermill). Wuttke is indeed the perfect man to take scientists by the hand and guide them towards the bright future of reproducible and trustworthy science.
Now, his PubPeer record is small, but it is his regular collaborators who provide clues where Wuttke might be getting his many papers from. The most famous coauthor from Wuttke’s Google Scholar profile is Mohammad Arjmand, professor at UBC in Canada, and a massive papermiller with contacts to the worst people.
Dr. Mohammad Arjmand showcases his work to German President Steinmeier
“The German President and delegation members also spoke with researchers working on challenges relating to clean energy,…”
Here one common paper:
Farhad Ahmadijokani , Hossein Molavi , Addie Bahi , Stefan Wuttke, Milad Kamkar , Orlando J. Rojas, Frank Ko , Mohammad Arjmand Electrospun nanofibers of chitosan/polyvinyl alcohol/UiO-66/nanodiamond: Versatile adsorbents for wastewater remediation and organic dye removal Chemical Engineering Journal (2023) doi: 10.1016/j.cej.2022.141176

Hoya camphorifolia: “….all five diffraction profiles are very similar (modulo a vertical elongation)… but EPN/T@U and ECPN/U have different low-angle segments, while ECPN/T and ECPN/N have different high-angle segments (which themselves share a subsegment).”
Another very problematic paper by Wuttke and the same set of coauthors (Ahmadijokani et al 2023) was corrected by Elsevier, as I reported in September 2023 Shorts. Here another dodgy paper of Wuttke and Arjmand:
Ahmadreza Ghaffarkhah , Seyyed Alireza Hashemi , Sara Rostami , Majed Amini , Farhad Ahmadijokani , Ali Pournaghshband Isfahani , Sameer E. Mhatre , Orlando J. Rojas , Milad Kamkar , Stefan Wuttke, Masoud Soroush , Mohammad Arjmand Ultra‐Flyweight Cryogels of MXene/Graphene Oxide for Electromagnetic Interference Shielding Advanced Functional Materials (2023) doi: 10.1002/adfm.202304748

Alexander Magazinov : “Incompatible scale bars between Figs. 5b and 5c (superimposed below to facilitate comparison).”
Wuttke authored many papers with Arjmand and his postdocs Ahmadreza Ghaffarkhah (PubPeer record), Farhad Ahmadijokani (PubPeer record) and Seyyed Alireza Hashemi (PubPeer record). Hashemi is an avid papermiller of his own standing, with absolutely no preferences for research topic (Frog stem cells?), who featured on this website several times and whose works are frequently struck by the Vickers Curse. And, this is interesting: he is also apparently associated with Wuttke’s EU4MOFs group:

Hashemi also often publishes with another major papermiller, Seeram Ramakrishna, for example:
Seyyed Alireza Hashemi , Seyyed Mojtaba Mousavi , Sonia Bahrani , Seeram Ramakrishna , Aziz Babapoor , Wei-Hung Chiang Coupled graphene oxide with hybrid metallic nanoparticles as potential electrochemical biosensors for precise detection of ascorbic acid within blood Analytica Chimica Acta (2020) doi: 10.1016/j.aca.2020.02.018 0


Papermilling with Hashemi and Ramakrishna eventually even brought a rector of a Swedish university into trouble, poor Anders Hagfeldt had to be whitewashed both in Sweden and in Switzerland where he worked before:
Swedish rector Anders Hagfeldt pronounced innocent of papermilling
“The board’s conclusion is therefore that the deviations regarding figure 2b and 2c in article 1 constitute serious deviations from good research practice”
This work of Hashemi’s was retracted for peer review fraud:
Seyyed Mojtaba Mousavi , Seyyed Alireza Hashemi , Ahmad Gholami , Navid Omidifar , Maryam Zarei , Sonia Bahrani , Khadije Yousefi , Wei-Hung Chiang , Aziz Babapoor Bioinorganic Synthesis of Polyrhodanine Stabilized FeO/Graphene Oxide in Microbial Supernatant Media for Anticancer and Antibacterial Applications Bioinorganic Chemistry and Applications (2021) doi: 10.1155/2021/9972664
“This article has been retracted by Hindawi, as publisher, following an investigation undertaken by the publisher [1]. This investigation has uncovered evidence of systematic manipulation of the publication and peer-review process. We cannot, therefore, vouch for the reliability or integrity of this article.”
Retraction, 6 December 2023
You are what your friends are, and Wuttke’s friends are Arjmand and Hashemi. You can imagine where these clever boys get their many research papers from. I told you, EU Commission couldn’t have made a better choice.
Retraction Watchdogging
Provincial Herb Festival
Elsewhere in Poland, a female professor was much less lucky with papermilling, and is suffering retractions!
This was the first one for Agnieszka Najda, associate professor for Vegetable Crops and Medicinal Plants at the University of Life Sciences in Lublin, as you see her coauthors are all from Pakistan, save for the Lubmin assitant professor Sylwia Wesołowska, who died in October 2023, before this paper was published:
Rokeya Akter , Agnieszka Najda , Md. Habibur Rahman , Muddaser Shah , Sylwia Wesołowska , Syed Shams Ul Hassan , Sidra Mubin , Parveen Bibi , Saeeda Saeeda Potential Role of Natural Products to Combat Radiotherapy and Their Future Perspectives. Molecules (2023) doi: 10.3390/molecules28248091
It was retracted in December 2023 for plagiarism of an earlier MDPI paper by Italian authors, Calvaruso et al 2019:
“This published review [1] has been retracted due to its significant overlap with a previously published review [2].
Following publication, the editorial office was contacted regarding the overlap. […]
The authors agree with this retraction.”

Najda must be buying from the cheapest Pakistani papermills. Here, she refused to agree to retraction:
Md. Mominur Rahman , Shabana Bibi , Md. Saidur Rahaman , Firoza Rahman , Fahadul Islam , Muhammad Saad Khan , Mohammad Mehedi Hasan , Anwar Parvez , Md. Abid Hossain , Saila Kabir Maeesa , Md. Rezaul Islam , Agnieszka Najda , Hamdan S. Al-malky , Hanan R.H. Mohamed , Hussah I.M. AlGwaiz , Aeshah A. Awaji , Mousa O. Germoush , Osama A. Kensara , Mohamed M. Abdel-Daim , Mohd Saeed , Mohammad Amjad Kamal Natural therapeutics and nutraceuticals for lung diseases: Traditional significance, phytochemistry, and pharmacology Biomedicine & Pharmacotherapy (2022) doi: 10.1016/j.biopha.2022.113041
The retraction from 6 March 2026 was for tortured phrases:
“An investigation conducted on behalf of the journal by Elsevier’s Research Integrity & Publishing Ethics team found phrases that make some passages in the article difficult to parse because they deviate from standard technical terms. The authors were requested to explain the use of these passages of text but were unable to do so. The Editor has lost confidence in the conclusions of the article and has determined it should be retracted.
The authors disagree with retraction and dispute the grounds for it.”
Sons of Poland
“Jeszcze Polska nie zginęła, Kiedy my żyjemy. Co nam obca przemoc dała, odpłacimy fabrykom artykułów.
Also here Najda’s coauthors are from Pakistan, India, Bangladesh, Egypt and Saudi Arabia:
Priti Tagde , Pooja Tagde , Sandeep Tagde , Tanima Bhattacharya , Vishal Garg , Rokeya Akter , Md. Habibur Rahman , Agnieszka Najda , Ghadeer M. Albadrani , Amany A. Sayed , Muhammad Furqan Akhtar , Ammara Saleem , Ahmed E. Altyar , Deepak Kaushik , Mohamed M. Abdel-Daim Natural bioactive molecules: An alternative approach to the treatment and control of glioblastoma multiforme Biomedicine & Pharmacotherapy (2021) doi: 10.1016/j.biopha.2021.111928
This retraction from 7 March 2026 was for irrelevant references, a classic feature of papermill business:”an investigation conducted by Elsevier’s Research Integrity & Publishing Ethics team on behalf of the journal identified references that are irrelevant to the article“. Again, the authors again didn’t agree to the retraction.
In the same Elsevier journal undergoing spring cleaning, another interesting retraction notice:
Partha Biswas , Shakil Ahmed Polash , Dipta Dey , Md. Abu Kaium , Aar Rafi Mahmud , Farhana Yasmin , Sumit Kumar Baral , Md. Aminul Islam , Tanjim Ishraq Rahaman , Asif Abdullah , Tanzila Ismail Ema , Dhrubo Ahmed Khan , Shabana Bibi, Hitesh Chopra , Mohamed Kamel , Agnieszka Najda , Maged M.A. Fouda , UmmeSalma M. Rehan , Mayyadah Mheidat , Rawidh Alsaidalani , Mohamed M. Abdel-Daim Md. Nazmul Hasan Advanced implications of nanotechnology in disease control and environmental perspectives Biomedicine & Pharmacotherapy (2023) doi: 10.1016/j.biopha.2022.114172
The March 2026 retraction was caused by Shakil Ahmed Polash being investigated by his Australian employer, and determined that most authorships were sold:
“The journal was contacted by RMIT University following an institutional investigation which found that Shakil Ahmed Polash did not qualify for authorship on this article, and requested a corrigendum to this article. The Authors were contacted and asked to respond.
As part of the investigation into this matter, the Journal found that Md. Abu Kaium, Aar Rafi Mahmud, Farhana Yasmin, Sumit Kumar Baral, Md. Aminul Islam, Tanjim Ishraq Rahaman, Asif Abdullah, Tanzila Ismail Ema, and Dhrubo Ahmed Khan also did not meet the journal requirements for authorship. Authorship should be limited to those who have made a significant contribution to the conception, design, execution or interpretation of the reported study, and the authors’ response was not sufficient to convince the Editor that those listed above met those requirements.
Furthermore, the Journal discovered unjustified changes in authorship between the original submission and the revised version. During revision, two authors (Maged M. A. Fouda and UmmeSalma M. Rehan) were added without explanation and without exceptional approval by the Editor, which is contrary to the Journal policy on changes to authorship.”
The Vickers Curse: secret revealed!
How did an editorial about insect pheromone communication get to receive 1200 irrelevant citations, almost all from papermills? Alexander Magazinov reveals The Secret of The Vickers Curse!
Poor Polash is likely about to lose his job, but what about Najda? She works with the worst criminals like Shafaqat Ali (e.g., Ahmad et al 2021), and has currently a total of 8 papers on PubPeer. Her papermill fabrication Tagde et al 2021 (with Lublin colleague Natalia Kot) was struck by the Vickers Curse, this one (with Najda’s head of department, Renata Nurzyńska-Wierdak) contains image fraud:
Shareen Singh , Thakur Gurjeet Singh , Manjinder Singh , Agnieszka Najda , Renata Nurzyńska-Wierdak , Rafa Almeer , Mohamed Kamel , Mohamed M. Abdel-Daim Anticonvulsive Effects of Chondroitin Sulfate on Pilocarpine and Pentylenetetrazole Induced Epileptogenesis in Mice Molecules (2021) doi: 10.3390/molecules26226773

Actinopolyspora biskrensis: “Two images in Figure 5 seem to be the same (cropped slightly differently), although they are described differently.”
The only good thing is that no animals were tortured there, it’s all made up.

Donate!
If you are interested to support my work, you can leave here a small tip of $5. Or several of small tips, just increase the amount as you like (2x=€10; 5x=€25). Your generous patronage of my journalism will be most appreciated!
€5.00





Agnieszka Najda has an amazing set of co-authors:
Shaker A. Mousa (Albany College of Pharmacy and Health Sciences, USA) 19 retractions
Shafaqat Ali (Government College University, Faisalabad, China Medical University) 17 retractions
Ammara Saleem (Government College University, Faisalabad, Pakistan) 13 retractions
Riaz Ullah (King Saud University, Saudi Arabia) 12 retractions
Tapan Behl (Chitkara University, India) 12 retractions
Simona Bungau (University of Oradea, Romania) 11 retractions
Hesham R. El-Seedi (Uppsala University, Menoufia University, Jiangsu University) 8 retractions
Mohamed M. Abdel‐Daim (King Saud University, Saudi Arabia) 8 retractions
Fahadul Islam (Daffodil International University, Dhaka, Bangladesh) 7 retractions
Sezai Ercisli (Atatürk University, Turkey) 7 retractions
Muhammad Rizwan (Government College University, Faisalabad, Pakistan) 7 retractions
Aayush Sehgal (Chitkara University, India) 6 retractions
It is a closed circle. There are dozens of researchers in Polish agricultural universities (usually called universities of life sciences) publishing with these crooks. Note also that, for example, Sezai Ercisli was a frequent co-author of Grzegorz Królczyk.
Another interesting circle constitutes Javad Sharifi-Rad (105 publications with Polish co-authors, 2 already retracted) and his associates, such as Abhijit Dey, Manoj Kumar, Shakeel Ahmad, Bahare Salehi. See e.g. this one:
RETRACTED ARTICLE: Human microbiome and homeostasis: insights into the key role of prebiotics, probiotics, and symbiotics: Critical Reviews in Food Science and Nutrition: Vol 61, No 9
Note the journal – Amin Mousavi Khaneghah was a member of the editorial board at Critical Reviews in Food Science and Nutrition until the end of December, but disapeared after I reported his misconduct to the EiC.
There are also dozens on reserchers in Polish agricultural universities publishing with Amin and his associates – Jose Manuel Lorenzo, Francisco Jose Barba. They are also connected with Javad’s group.
Nobody cares. Their universities are happy that they bring “excellent” publications, which can be included in evaluation reports. Business is booming. Money is flowing – from Polish taxpayers to Ministry of Science and Higher Education, from MNiSW to universities, from universities to the pockets of papermillers.
LikeLike
Careful with people named Muhammad Rizwan. There are many different guys of this name on PubPeer
LikeLike
How many in Government College University, Faisalabad? RW database list 1.
LikeLike
First PubPeer hit, and it’s apparently a different M Rizwan,
Centre for Biotechnology and Microbiology, University of Swat
https://pubpeer.com/publications/811293F10E6EEDFB23EC9C264F47DC
LikeLike
But Agnieszka Najda published only with Muhammad Rizwan from Government College University in Faisalabad (also alma mater of Shafaqat Ali). I’m well aware of the popularity of some Pakistani names. Remember that there were 12 Muhammads Bilals on PubPeer? I always check affiliation – both on PubPeer and on retracted articles. In critical cases also Scopus ID and ORCID account.
LikeLiked by 1 person
Professor Agnieszka Najda yestarday received the Vth retracion notice. Review article with 16 co-authors! In Biomedicine and Pharmacotherapy 2021. Cause: bibliography manipulation.
LikeLiked by 1 person
Prof. Najda has 12 more articles in this journal – 9 of them reviews. How many more will be taken down?
LikeLike
I was right. Biomedicine & Pharmacotherapy has retracted another article co-authored by Agnieszka Najda.
RETRACTED: Multiple strategies with the synergistic approach for addressing colorectal cancer – ScienceDirect
It’s #6. She caught up with Królczyk.
https://www.sciencedirect.com/science/article/pii/S0753332221004868?via%3Dihub
LikeLike
“Also in the enxt case”
LikeLike
Thanks, corrected!
I should install Grammarly and have a virtual Ivan Oransky check my texts…
LikeLike
Wow, that Grammarly feature pushes forwards the border of “unthinkably stupid”.
You should definitelly get it, but first ask Grammarly to also re-create you as an AI expert.
LikeLike
In Fig. 1 there are 6 reused images. Photos H and I (left panel) are photos G and H (right panel)
LikeLike
Which paper?
LikeLike
The second group of images under the title “First dentist ever” commented by Dysdera arabisenen
LikeLiked by 1 person